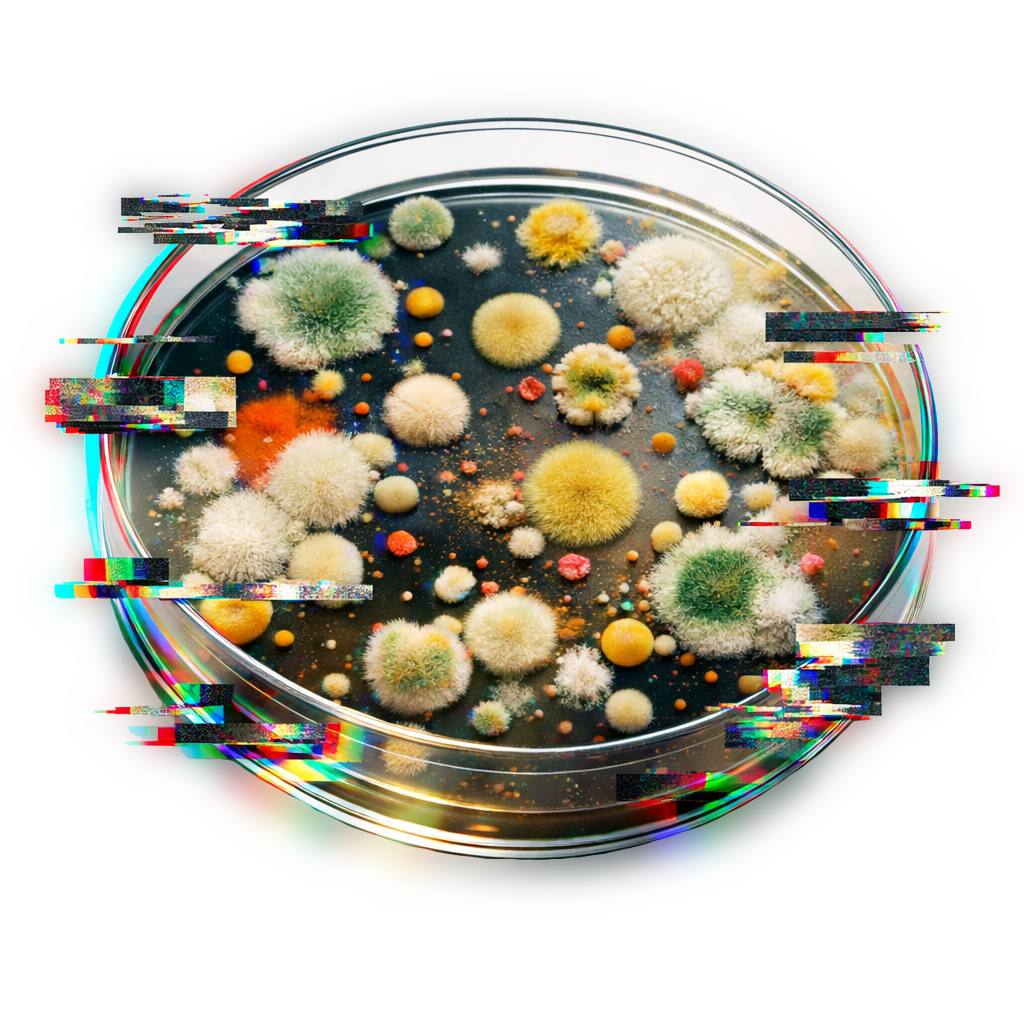

3 lépésben labor-kompatibilis eredmény
Automatikus kolónia-detektálás és -mérés nagyfelbontású képekből, kalibrációval, morfológiai jellemzőkkel és CFU-számítással. Kifejezetten oktatási és labor-gyakorlatok standardizálására tervezve.



CFU Érték meghatározása röviden



Kolóniák Elemzése Hatékonyan
Hogyan elemezzünk kolóniákat, hogyan értelmezzük a kolóniákat morfológiai szempontból
Célunk
Egy olyan rendszer üzemeltetése, amely a biológiai mintákról készült képekből webes felületen automatikusan megszámolja és megjelölje a kolóniákat, majd kalibráció alapján valós méret- és morfológiai kiértékelést ad. A projekt célja egy reprodukálható, oktatásban is használható rendszer létrehozása, amely standardizálja a kiértékelést és támogatja a CFU/mL számítást, valamint az eredmények áttekinthető bemutatását.
